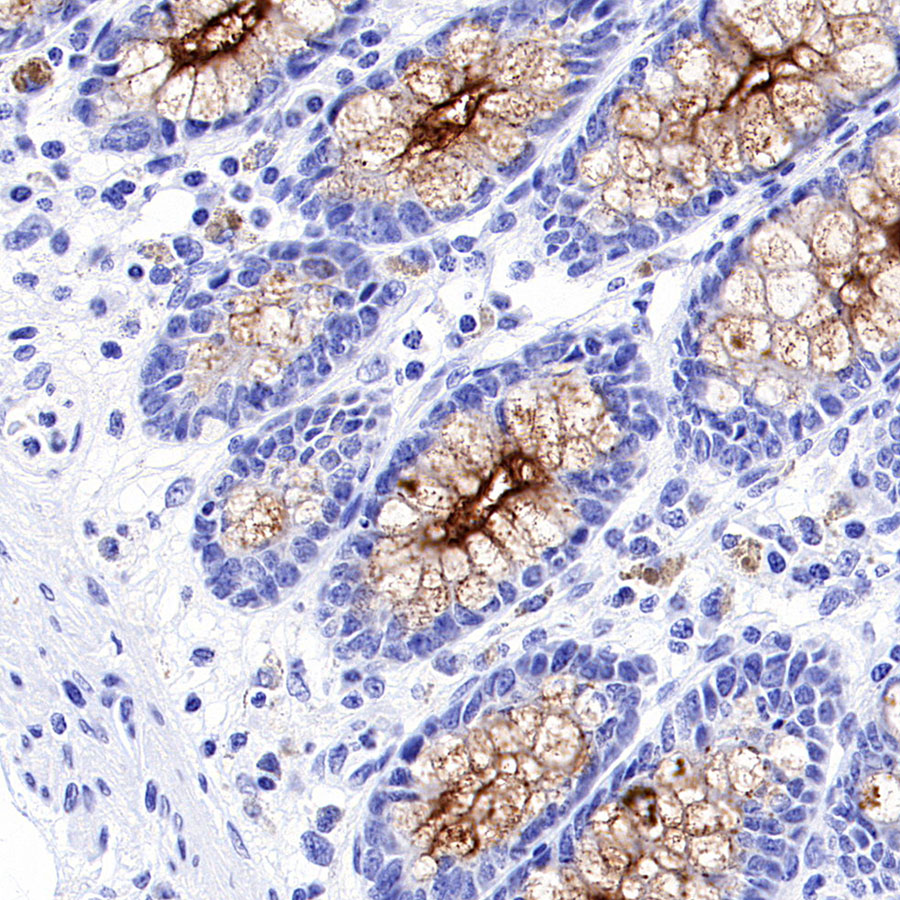
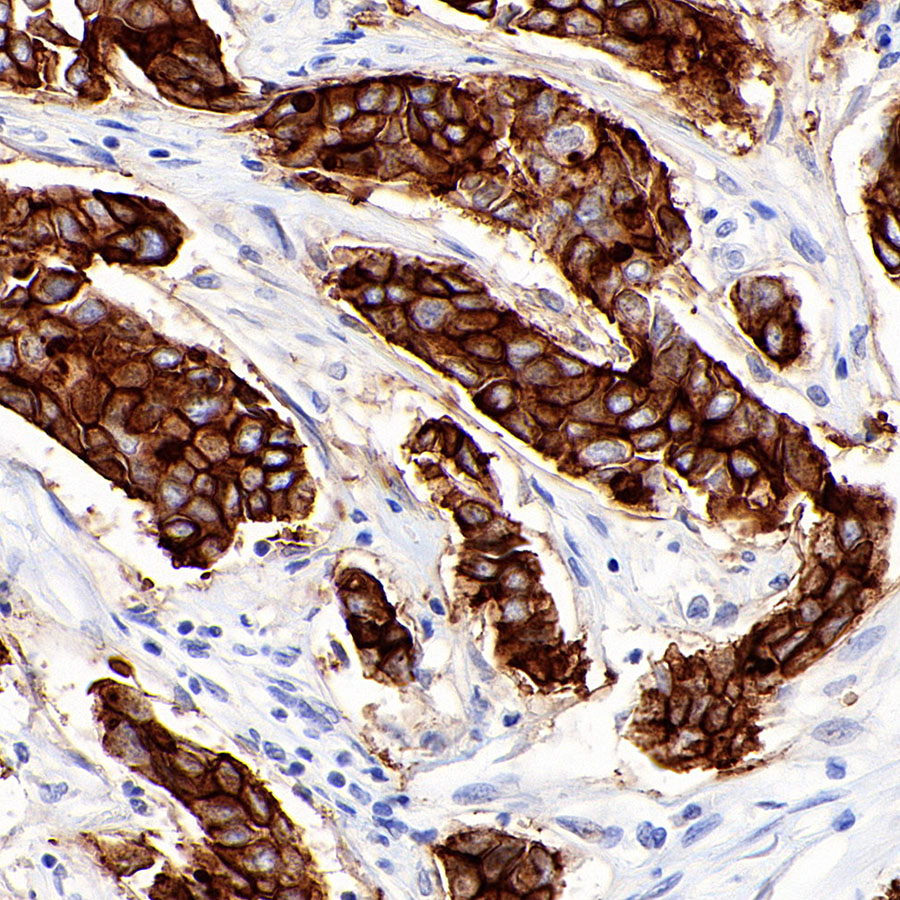

worldwide@absin.cn
- Cart 0
- English
Mouse anti-MUC1 Monoclonal Antibody(777-71)
Mucin-1; MUC-1; Breast carcinoma-associated antigen DF3; Cancer antigen 15-3 (CA 15-3); Carcinoma-associated mucin; Episialin; H23AG; Krebs von den Lungen-6 (KL-6); PEMT; Peanut-reactive urinary mucin (PUM); Polymorphic epithelial mucin (PEM); Tumor-associated epithelial membrane antigen (EMA); Tumor-associated mucin,MUC1

Reactivity:
Human, Mouse, Rat
Application:
WB, IP, IHC-P, IF, ICC, FCM(Intra)
more>>Host:
Mouse
Clonality:
Monoclonal Antibody

- Product Details
- FAQ
- Pictures
- Documents
Tips : This product is for research use only. Not for use in diagnostic prodcedures.